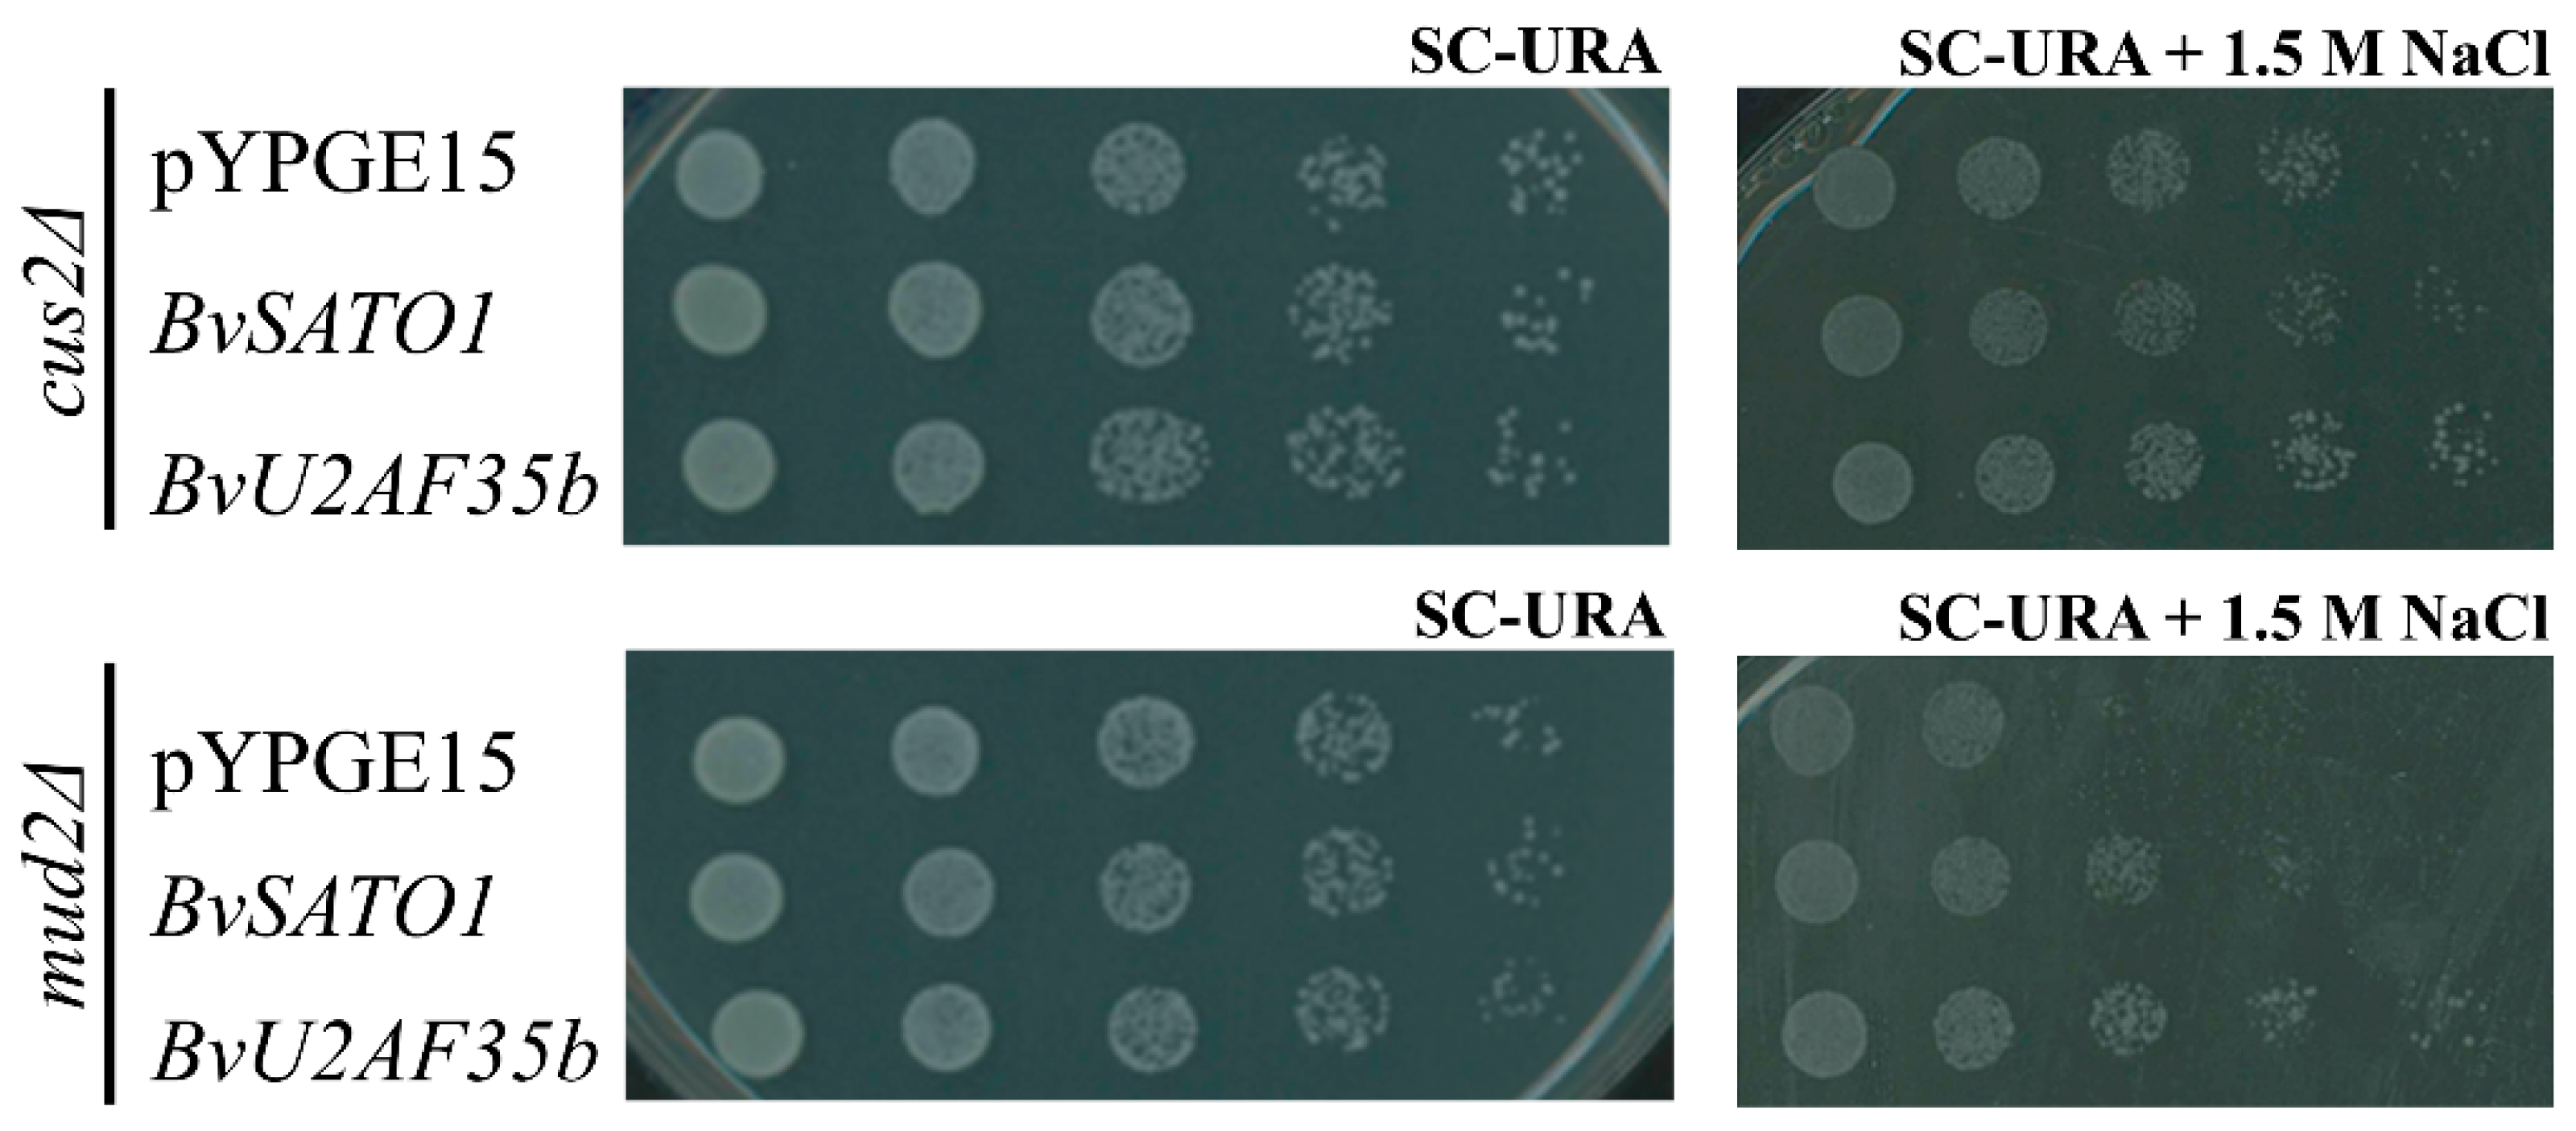
Agronomy 10 00250 g003

RNA-Binding Proteins as Targets to Improve Salt Stress Tolerance in Crops
Abstract
1. Introduction
2. Materials and Methods
2.1. Plant Material, Yeast Strains and Culture Conditions
2.2. Construction of the Sugar Beet cDNA Library Induced by Salt Stress and Isolation of cDNA Clones conferring Salt Tolerance to Yeast
2.3. Cloning of BvSATO1 and Plant Transformation
2.4. Southern Blot and RNA Expression Analysis
3. Results
3.1. Isolation and Molecular Characterisation of Sugar Beet Genes Conferring Salt Tolerance to Yeast
3.2. BvU2AF35b Improves Growth of Yeast Mutants with Impaired Splicing under Salt Stress
3.3. BvU2AF35b Increases the Expression of Genes Related to the Response to Osmotic Stress in Yeast
3.4. BvSATO1 Is Repressed by Salt Treatment in Sugar Beet and Its Expression in Arabidopsis Increases Salt Tolerance
4. Discussion
5. Conclusions
Supplementary Materials
Author Contributions
Funding
Acknowledgments
Conflicts of Interest
References
- Munns, R.; Day, D.A.; Fricke, W.; Watt, M.; Arsova, B.; Barkla, B.J.; Bose, J.; Byrt, C.S.; Chen, Z.H.; Foster, K.J.; et al. Energy costs of salt tolerance in crop plants. New Phytol. 2019, 225, 1072–1090. [Google Scholar] [CrossRef] [PubMed]
- Munns, R.; Tester, M. Mechanisms of salinity tolerance. Annu. Rev. Plant. Biol. 2008, 59, 651–681. [Google Scholar] [CrossRef] [PubMed]
- Vinocur, B.; Altman, A. Recent advances in engineering plant tolerance to abiotic stress: Achievements and limitations. Curr. Opin. Biotechnol. 2005, 16, 123–132. [Google Scholar] [CrossRef] [PubMed]
- Blumwald, E. Sodium transport and salt tolerance in plants. Curr. Opin. Cell Biol. 2000, 12, 431–434. [Google Scholar] [CrossRef]
- Serrano, R. Salt tolerance in plants and microorganisms: Toxicity targets and defense responses. Int. Rev. Cytol. 1996, 165, 1–52. [Google Scholar]
- Yamaguchi, T.; Blumwald, E. Developing salt-tolerant crop plants: Challenges and opportunities. Trends Plant Sci. 2005, 10, 615–620. [Google Scholar] [CrossRef]
- Zhu, J.K. Salt and drought stress signal transduction in plants. Annu. Rev. Plant. Biol. 2002, 53, 247–273. [Google Scholar] [CrossRef]
- Hasegawa, P.M.; Bressan, R.A.; Zhu, J.K.; Bohnert, H.J. Plant Cellular and Molecular Responses to High Salinity. Annu. Rev. Plant Physiol. Plant Mol. Biol. 2000, 51, 463–499. [Google Scholar] [CrossRef]
- Parida, A.K.; Das, A.B. Salt tolerance and salinity effects on plants: A review. Ecotoxicol. Environ. Saf. 2005, 60, 324–349. [Google Scholar] [CrossRef]
- Guo, Y.; Qiu, Q.S.; Quintero, F.J.; Pardo, J.M.; Ohta, M.; Zhang, C.; Schumaker, K.S.; Zhu, J.K. Transgenic evaluation of activated mutant alleles of SOS2 reveals a critical requirement for its kinase activity and C-terminal regulatory domain for salt tolerance in Arabidopsis thaliana. Plant Cell 2004, 16, 435–449. [Google Scholar] [CrossRef]
- Shi, H.; Lee, B.H.; Wu, S.J.; Zhu, J.K. Overexpression of a plasma membrane Na+/H+ antiporter gene improves salt tolerance in Arabidopsis thaliana. Nat. Biotechnol. 2003, 21, 81–85. [Google Scholar] [CrossRef] [PubMed]
- Zhu, J.K. Regulation of ion homeostasis under salt stress. Curr. Opin. Plant Biol. 2003, 6, 441–445. [Google Scholar] [CrossRef]
- Batool, S.; Uslu, V.V.; Rajab, H.; Ahmad, N.; Waadt, R.; Geiger, D.; Malagoli, M.; Xiang, C.B.; Hedrich, R.; Rennenberg, H.; et al. Sulfate is Incorporated into Cysteine to Trigger ABA Production and Stomatal Closure. Plant Cell 2018, 30, 2973–2987. [Google Scholar] [CrossRef] [PubMed]
- Fujii, H.; Chinnusamy, V.; Rodrigues, A.; Rubio, S.; Antoni, R.; Park, S.Y.; Cutler, S.R.; Sheen, J.; Rodriguez, P.L.; Zhu, J.K. In vitro reconstitution of an abscisic acid signalling pathway. Nature 2009, 462, 660–664. [Google Scholar] [CrossRef]
- Geiger, D.; Scherzer, S.; Mumm, P.; Stange, A.; Marten, I.; Bauer, H.; Ache, P.; Matschi, S.; Liese, A.; Al-Rasheid, K.A.; et al. Activity of guard cell anion channel SLAC1 is controlled by drought-stress signaling kinase-phosphatase pair. Proc. Natl. Acad. Sci. USA 2009, 106, 21425–21430. [Google Scholar] [CrossRef]
- Kang, J.Y.; Choi, H.I.; Im, M.Y.; Kim, S.Y. Arabidopsis basic leucine zipper proteins that mediate stress-responsive abscisic acid signaling. Plant Cell 2002, 14, 343–357. [Google Scholar] [CrossRef]
- Nakashima, K.; Shinwari, Z.K.; Sakuma, Y.; Seki, M.; Miura, S.; Shinozaki, K.; Yamaguchi-Shinozaki, K. Organization and expression of two Arabidopsis DREB2 genes encoding DRE-binding proteins involved in dehydration- and high-salinity-responsive gene expression. Plant Mol. Biol. 2000, 42, 657–665. [Google Scholar] [CrossRef]
- Park, S.Y.; Fung, P.; Nishimura, N.; Jensen, D.R.; Fujii, H.; Zhao, Y.; Lumba, S.; Santiago, J.; Rodrigues, A.; Chow, T.F.; et al. Abscisic acid inhibits type 2C protein phosphatases via the PYR/PYL family of START proteins. Science 2009, 324, 1068–1071. [Google Scholar] [CrossRef]
- Apse, M.P.; Aharon, G.S.; Snedden, W.A.; Blumwald, E. Salt tolerance conferred by overexpression of a vacuolar Na+/H+ antiport in Arabidopsis. Science 1999, 285, 1256–1258. [Google Scholar] [CrossRef]
- Ren, Z.H.; Gao, J.P.; Li, L.G.; Cai, X.L.; Huang, W.; Chao, D.Y.; Zhu, M.Z.; Wang, Z.Y.; Luan, S.; Lin, H.X. A rice quantitative trait locus for salt tolerance encodes a sodium transporter. Nat. Genet. 2005, 37, 1141–1146. [Google Scholar] [CrossRef]
- Sakamoto, H.; Maruyama, K.; Sakuma, Y.; Meshi, T.; Iwabuchi, M.; Shinozaki, K.; Yamaguchi-Shinozaki, K. Arabidopsis Cys2/His2-type zinc-finger proteins function as transcription repressors under drought, cold, and high-salinity stress conditions. Plant Physiol. 2004, 136, 2734–2746. [Google Scholar] [CrossRef] [PubMed]
- Taji, T.; Ohsumi, C.; Iuchi, S.; Seki, M.; Kasuga, M.; Kobayashi, M.; Yamaguchi-Shinozaki, K.; Shinozaki, K. Important roles of drought- and cold-inducible genes for galactinol synthase in stress tolerance in Arabidopsis thaliana. Plant J. 2002, 29, 417–426. [Google Scholar] [CrossRef] [PubMed]
- Urao, T.; Yamaguchi-Shinozaki, K.; Shinozaki, K. Two-component systems in plant signal transduction. Trends Plant Sci. 2000, 5, 67–74. [Google Scholar] [CrossRef]
- Yoo, J.H.; Park, C.Y.; Kim, J.C.; Heo, W.D.; Cheong, M.S.; Park, H.C.; Kim, M.C.; Moon, B.C.; Choi, M.S.; Kang, Y.H.; et al. Direct interaction of a divergent CaM isoform and the transcription factor, MYB2, enhances salt tolerance in arabidopsis. J. Biol. Chem. 2005, 280, 3697–3706. [Google Scholar] [CrossRef] [PubMed]
- Fabregas, N.; Lozano-Elena, F.; Blasco-Escamez, D.; Tohge, T.; Martinez-Andujar, C.; Albacete, A.; Osorio, S.; Bustamante, M.; Riechmann, J.L.; Nomura, T.; et al. Overexpression of the vascular brassinosteroid receptor BRL3 confers drought resistance without penalizing plant growth. Nat. Commun. 2018, 9, 4680. [Google Scholar] [CrossRef]
- Takagi, H.; Tamiru, M.; Abe, A.; Yoshida, K.; Uemura, A.; Yaegashi, H.; Obara, T.; Oikawa, K.; Utsushi, H.; Kanzaki, E.; et al. MutMap accelerates breeding of a salt-tolerant rice cultivar. Nat. Biotechnol. 2015, 33, 445–449. [Google Scholar] [CrossRef]
- Zhang, J.Z.; Creelman, R.A.; Zhu, J.K. From laboratory to field. Using information from Arabidopsis to engineer salt, cold, and drought tolerance in crops. Plant Physiol. 2004, 135, 615–621. [Google Scholar] [CrossRef]
- Zhang, M.; Cao, Y.; Wang, Z.; Wang, Z.Q.; Shi, J.; Liang, X.; Song, W.; Chen, Q.; Lai, J.; Jiang, C. A retrotransposon in an HKT1 family sodium transporter causes variation of leaf Na(+) exclusion and salt tolerance in maize. New Phytol. 2018, 217, 1161–1176. [Google Scholar] [CrossRef]
- Greenway, H.; Munns, R. Mechanisms of salt tolerance in nonhalophytes. Annu. Rev. Plant Physiol. 1980, 31, 149–190. [Google Scholar] [CrossRef]
- Kanhonou, R.; Serrano, R.; Palau, R.R. A catalytic subunit of the sugar beet protein kinase CK2 is induced by salt stress and increases NaCl tolerance in Saccharomyces cerevisiae. Plant Mol. Biol. 2001, 47, 571–579. [Google Scholar] [CrossRef]
- Rausell, A.; Kanhonou, R.; Yenush, L.; Serrano, R.; Ros, R. The translation initiation factor eIF1A is an important determinant in the tolerance to NaCl stress in yeast and plants. Plant J. 2003, 34, 257–267. [Google Scholar] [CrossRef] [PubMed]
- Serrano, R.; Gaxiola, R.; Rios, G.; Forment, J.; Vicente, O.; Ros, R. Salt stress proteins identified by a functional approach in yeast. Chem. Mon. 2003, 134, 1445–1464. [Google Scholar] [CrossRef]
- Fedoroff, N.V. RNA-binding proteins in plants: The tip of an iceberg? Curr. Opin. Plant Biol. 2002, 5, 452–459. [Google Scholar] [CrossRef]
- Lorkovic, Z.J. Role of plant RNA-binding proteins in development, stress response and genome organization. Trends Plant Sci. 2009, 14, 229–236. [Google Scholar] [CrossRef] [PubMed]
- Albà, M.M.; Pagès, M. Plant proteins containing the RNA-recognition motif. Trends Plant Sci. 1998, 3, 15–21. [Google Scholar] [CrossRef]
- Burd, C.G.; Dreyfuss, G. Conserved structures and diversity of functions of RNA-binding proteins. Science 1994, 265, 615–621. [Google Scholar] [CrossRef] [PubMed]
- Lorkovic, Z.J.; Barta, A. Genome analysis: RNA recognition motif (RRM) and K homology (KH) domain RNA-binding proteins from the flowering plant Arabidopsis thaliana. Nucleic Acids Res. 2002, 30, 623–635. [Google Scholar] [CrossRef]
- Nakaminami, K.; Matsui, A.; Shinozaki, K.; Seki, M. RNA regulation in plant abiotic stress responses. Biochim. Biophys. Acta 2012, 1819, 149–153. [Google Scholar] [CrossRef]
- Ambrosone, A.; Batelli, G.; Nurcato, R.; Aurilia, V.; Punzo, P.; Bangarusamy, D.K.; Ruberti, I.; Sassi, M.; Leone, A.; Costa, A.; et al. The Arabidopsis RNA-binding protein AtRGGA regulates tolerance to salt and drought stress. Plant Physiol. 2015, 168, 292–306. [Google Scholar] [CrossRef]
- Ambrosone, A.; Costa, A.; Leone, A.; Grillo, S. Beyond transcription: RNA-binding proteins as emerging regulators of plant response to environmental constraints. Plant Sci. 2012, 182, 12–18. [Google Scholar] [CrossRef]
- Ambrosone, A.; Costa, A.; Martinelli, R.; Massarelli, I.; de Simone, V.; Grillo, S.; Leone, A. Differential gene regulation in potato cells and plants upon abrupt or gradual exposure to water stress. Acta Physiol. Plantatrum 2011, 33, 1157–1171. [Google Scholar] [CrossRef]
- Amorim, M.d.; Willing, E.M.; Szabo, E.X.; Francisco-Mangilet, A.G.; Droste-Borel, I.; Macek, B.; Schneeberger, K.; Laubinger, S. The U1 snRNP Subunit LUC7 Modulates Plant Development and Stress Responses via Regulation of Alternative Splicing. Plant Cell 2018, 30, 2838–2854. [Google Scholar] [CrossRef]
- Sorenson, R.; Bailey-Serres, J. Selective mRNA sequestration by OLIGOURIDYLATE-BINDING PROTEIN 1 contributes to translational control during hypoxia in Arabidopsis. Proc. Natl. Acad. Sci. USA 2014, 111, 2373–2378. [Google Scholar] [CrossRef]
- Frey, N.F.d.; Muller, P.; Jammes, F.; Kizis, D.; Leung, J.; Perrot-Rechenmann, C.; Bianchi, M.W. The RNA binding protein Tudor-SN is essential for stress tolerance and stabilizes levels of stress-responsive mRNAs encoding secreted proteins in Arabidopsis. Plant Cell 2010, 22, 1575–1591. [Google Scholar] [CrossRef]
- Forment, J.; Naranjo, M.A.; Roldan, M.; Serrano, R.; Vicente, O. Expression of Arabidopsis SR-like splicing proteins confers salt tolerance to yeast and transgenic plants. Plant J. 2002, 30, 511–519. [Google Scholar] [CrossRef]
- Gu, J.; Xia, Z.; Luo, Y.; Jiang, X.; Qian, B.; Xie, H.; Zhu, J.K.; Xiong, L.; Zhu, J.; Wang, Z.Y. Spliceosomal protein U1A is involved in alternative splicing and salt stress tolerance in Arabidopsis thaliana. Nucleic Acids Res. 2018, 46, 1777–1792. [Google Scholar] [CrossRef] [PubMed]
- Kim, J.S.; Jung, H.J.; Lee, H.J.; Kim, K.A.; Goh, C.H.; Woo, Y.; Oh, S.H.; Han, Y.S.; Kang, H. Glycine-rich RNA-binding protein 7 affects abiotic stress responses by regulating stomata opening and closing in Arabidopsis thaliana. Plant J. 2008, 55, 455–466. [Google Scholar] [CrossRef] [PubMed]
- Wallis, J.W.; Chrebet, G.; Brodsky, G.; Rolfe, M.; Rothstein, R. A hyperrecombintion mutation in S. cerevisiae identifies a novel eukaryotic topoisomerase. Cell 1989, 58, 409–419. [Google Scholar] [CrossRef]
- Banuelos, M.A.; Sychrova, H.; Bleykasten-Grosshans, C.; Souciet, J.L.; Potier, S. The Nha1 antiporter of Saccharomyces cerevisiae mediates sodium and potassium efflux. Microbiology 1998, 144 Pt 10, 2749–2758. [Google Scholar]
- Garciadeblas, B.; Rubio, F.; Quintero, F.J.; Banuelos, M.A.; Haro, R.; Rodriguez-Navarro, A. Differential expression of two genes encoding isoforms of the ATPase involved in sodium efflux in Saccharomyces cerevisiae. Mol. Gen. Genet. 1993, 236, 363–368. [Google Scholar] [CrossRef]
- Brachmann, C.B.; Davies, A.; Cost, G.J.; Caputo, E.; Li, J.; Hieter, P.; Boeke, J.D. Designer Deletion Strains derived from Saccharomyces cerevisiae S288C: A Useful set of Strains and Plasmids for PCR-mediated Gene Disruption and Other Applications. Yeast 1998, 14, 115–132. [Google Scholar] [CrossRef]
- Gil-Mascarell, R.; Lopez-Coronado, J.M.; Belles, J.M.; Serrano, R.; Rodriguez, P.L. The Arabidopsis HAL2-like gene family includes a novel sodium-sensitive phosphatase. Plant J. 1999, 17, 373–383. [Google Scholar] [CrossRef] [PubMed]
- Brunelli, J.P.; Pall, M.L. A series of yeast/Escherichia coli lambda expression vectors designed for directional cloning of cDNAs and cre/lox-mediated plasmid excision. Yeast 1993, 9, 1309–1318. [Google Scholar] [CrossRef] [PubMed]
- Gietz, D.; Jean, A.S.; Woods, R.A.; Schiestl, R.H. Improved method for high efficiency transformation of intact yeast cells. Nucleic Acids Res. 1992, 20, 1425. [Google Scholar] [CrossRef] [PubMed]
- Bevan, M. Binary Agrobacterium vectors for plant transformation. Nucleic Acids Res. 1984, 12, 8711–8721. [Google Scholar] [CrossRef] [PubMed]
- Deblaere, R.; Bytebier, B.; de Greve, H.; Deboeck, F.; Schell, J.; van Montagu, M.; Leemans, J. Efficient octopine Ti plasmid-derived vectors for Agrobacterium-mediated gene transfer to plants. Nucleic Acids Res. 1985, 13, 4777–4788. [Google Scholar] [CrossRef]
- Clough, S.J.; Bent, A.F. Floral dip: A simplified method for Agrobacterium-mediated transformation of Arabidopsis thaliana. Plant J. 1998, 16, 735–743. [Google Scholar] [CrossRef]
- Garre, E.; Romero-Santacreu, L.; Barneo-Munoz, M.; Miguel, A.; Perez-Ortin, J.E.; Alepuz, P. Nonsense-mediated mRNA decay controls the changes in yeast ribosomal protein pre-mRNAs levels upon osmotic stress. PLoS ONE 2013, 8, e61240. [Google Scholar] [CrossRef]
- Wang, B.B.; Brendel, V. Molecular characterization and phylogeny of U2AF35 homologs in plants. Plant Physiol. 2006, 140, 624–636. [Google Scholar] [CrossRef]
- Dohm, J.C.; Minoche, A.E.; Holtgrawe, D.; Capella-Gutierrez, S.; Zakrzewski, F.; Tafer, H.; Rupp, O.; Sorensen, T.R.; Stracke, R.; Reinhardt, R.; et al. The genome of the recently domesticated crop plant sugar beet (Beta vulgaris). Nature 2014, 505, 546–549. [Google Scholar] [CrossRef]
- Berglund, J.A.; Chua, K.; Abovich, N.; Reed, R.; Rosbash, M. The splicing factor BBP interacts specifically with the pre-mRNA branchpoint sequence UACUAAC. Cell 1997, 89, 781–787. [Google Scholar] [CrossRef]
- Wang, Q.; Zhang, L.; Lynn, B.; Rymond, B.C. A BBP-Mud2p heterodimer mediates branchpoint recognition and influences splicing substrate abundance in budding yeast. Nucleic Acids Res. 2008, 36, 2787–2798. [Google Scholar] [CrossRef] [PubMed]
- Simpson, G.G.; Clark, G.P.; Rothnie, H.M.; Boelens, W.; van Venrooij, W.; Brown, J.W. Molecular characterization of the spliceosomal proteins U1A and U2B" from higher plants. EMBO J. 1995, 14, 4540–4550. [Google Scholar] [CrossRef] [PubMed]
- Xiong, F.; Ren, J.J.; Yu, Q.; Wang, Y.Y.; Lu, C.C.; Kong, L.J.; Otegui, M.S.; Wang, X.L. AtU2AF65b functions in abscisic acid mediated flowering via regulating the precursor messenger RNA splicing of ABI5 and FLC in Arabidopsis. New Phytol. 2019, 223, 277–292. [Google Scholar] [CrossRef]
- Mufarrege, E.F.; Gonzalez, D.H.; Curi, G.C. Functional interconnections of Arabidopsis exon junction complex proteins and genes at multiple steps of gene expression. J. Exp. Bot. 2011, 62, 5025–5036. [Google Scholar] [CrossRef] [PubMed]
- Boehm, V.; Gehring, N.H. Exon Junction Complexes: Supervising the Gene Expression Assembly Line. Trends Genet. 2016, 32, 724–735. [Google Scholar] [CrossRef]
- Chang, Y.F.; Imam, J.S.; Wilkinson, M.F. The nonsense-mediated decay RNA surveillance pathway. Annu. Rev. Biochem. 2007, 76, 51–74. [Google Scholar] [CrossRef]
- Tange, T.O.; Shibuya, T.; Jurica, M.S.; Moore, M.J. Biochemical analysis of the EJC reveals two new factors and a stable tetrameric protein core. RNA 2005, 11, 1869–1883. [Google Scholar] [CrossRef]
- Dostie, J.; Dreyfuss, G. Translation is required to remove Y14 from mRNAs in the cytoplasm. Curr. Biol. 2002, 12, 1060–1067. [Google Scholar] [CrossRef]
- Shi, H.; Xu, R.M. Crystal structure of the Drosophila Mago nashi-Y14 complex. Genes Dev. 2003, 17, 971–976. [Google Scholar] [CrossRef]
- Cilano, K.; Mazanek, Z.; Khan, M.; Metcalfe, S.; Zhang, X.N. A New Mutation, hap1-2, Reveals a C Terminal Domain Function in AtMago Protein and Its Biological Effects in Male Gametophyte Development in Arabidopsis thaliana. PLoS ONE 2016, 11, e0148200. [Google Scholar] [CrossRef] [PubMed]
- Muthuramalingam, M.; Wang, Y.; Li, Y.; Mahalingam, R. Interacting protein partners of Arabidopsis RNA-binding protein AtRBP45b. Plant Biol. 2017, 19, 327–334. [Google Scholar] [CrossRef] [PubMed]
- Heaton, J.H.; Dlakic, W.M.; Dlakic, M.; Gelehrter, T.D. Identification and cDNA cloning of a novel RNA-binding protein that interacts with the cyclic nucleotide-responsive sequence in the Type-1 plasminogen activator inhibitor mRNA. J. Biol. Chem. 2001, 276, 3341–3347. [Google Scholar] [CrossRef] [PubMed]
- Huang, L.; Grammatikakis, N.; Yoneda, M.; Banerjee, S.D.; Toole, B.P. Molecular characterization of a novel intracellular hyaluronan-binding protein. J. Biol. Chem. 2000, 275, 29829–29839. [Google Scholar] [CrossRef]
- Garre, E.; Pelechano, V.; del Pino, M.S.; Alepuz, P.; Sunnerhagen, P. The Lsm1-7/Pat1 complex binds to stress-activated mRNAs and modulates the response to hyperosmotic shock. PLoS Genet. 2018, 14, e1007563. [Google Scholar] [CrossRef]
- Garre, E.; Romero-Santacreu, L.; de Clercq, N.; Blasco-Angulo, N.; Sunnerhagen, P.; Alepuz, P. Yeast mRNA cap-binding protein Cbc1/Sto1 is necessary for the rapid reprogramming of translation after hyperosmotic shock. Mol. Biol. Cell 2012, 23, 137–150. [Google Scholar] [CrossRef]
- Romero-Santacreu, L.; Moreno, J.; Perez-Ortin, J.E.; Alepuz, P. Specific and global regulation of mRNA stability during osmotic stress in Saccharomyces cerevisiae. RNA 2009, 15, 1110–1120. [Google Scholar] [CrossRef]
- Canadell, D.; Garcia-Martinez, J.; Alepuz, P.; Perez-Ortin, J.E.; Arino, J. Impact of high pH stress on yeast gene expression: A comprehensive analysis of mRNA turnover during stress responses. Biochim. Biophys. Acta 2015, 1849, 653–664. [Google Scholar] [CrossRef]

| Gene Name | GenBank or NCBI Accession Number | Times Isolated | Amino Acids | RNA Binding Motifs | Homologs in Arabidopsis | Yeast Homologues | E Value | Predicted Functions |
|---|---|---|---|---|---|---|---|---|
| BvSATO1 | CAC85227.1 | 6 | 356 | RGG, RE, RD | At4g16830 (AtRGGA) | – | – | RNA stability, storage or translation |
| BvSATO2 | XP_010677113.1 | 1 | 356 | RGG, RE, RD | At4g16830 (AtRGGA) | – | – | RNA stability, storage or translation |
| BvSATO3 | CAC85244.1 | 1 | 342 | Pro-rich, Zn-finger | At5g51410 (AtLuc7) | Luc7p | E-20 | U1 snRNA associated protein. Involved in Splicing |
| BvSATO4 | XP_010673688.1 | 1 | 203 | RRM | At1g51510 (AtY14) | Rna15p | E-6 | Member of the exon junction complex: Intron mediated enhanced gene expression, nonsense-mediated mRNA decay |
| BvSATO6 | CAC85246.1 | 1 | 323 | Three RRM | At1g11650 (AtRBP45) | Nam8p | E-50 | RNA stability |
| BvU2AF35b | XP_010683884.1 | 3 | 310 | RRM, Two Zn-finger | At5g42820 (AtU2AF35) | – | – | U2 snRNA associated protein. Involved in splicing |
© 2020 by the authors. Licensee MDPI, Basel, Switzerland. This article is an open access article distributed under the terms and conditions of the Creative Commons Attribution (CC BY) license (http://creativecommons.org/licenses/by/4.0/).
Share and Cite
Rosa Téllez, S.; Kanhonou, R.; Castellote Bellés, C.; Serrano, R.; Alepuz, P.; Ros, R. RNA-Binding Proteins as Targets to Improve Salt Stress Tolerance in Crops. Agronomy 2020, 10, 250. https://doi.org/10.3390/agronomy10020250
Rosa Téllez S, Kanhonou R, Castellote Bellés C, Serrano R, Alepuz P, Ros R. RNA-Binding Proteins as Targets to Improve Salt Stress Tolerance in Crops. Agronomy. 2020; 10(2):250. https://doi.org/10.3390/agronomy10020250
Chicago/Turabian StyleRosa Téllez, Sara, Rodoldphe Kanhonou, Carlos Castellote Bellés, Ramón Serrano, Paula Alepuz, and Roc Ros. 2020. "RNA-Binding Proteins as Targets to Improve Salt Stress Tolerance in Crops" Agronomy 10, no. 2: 250. https://doi.org/10.3390/agronomy10020250
APA StyleRosa Téllez, S., Kanhonou, R., Castellote Bellés, C., Serrano, R., Alepuz, P., & Ros, R. (2020). RNA-Binding Proteins as Targets to Improve Salt Stress Tolerance in Crops. Agronomy, 10(2), 250. https://doi.org/10.3390/agronomy10020250

